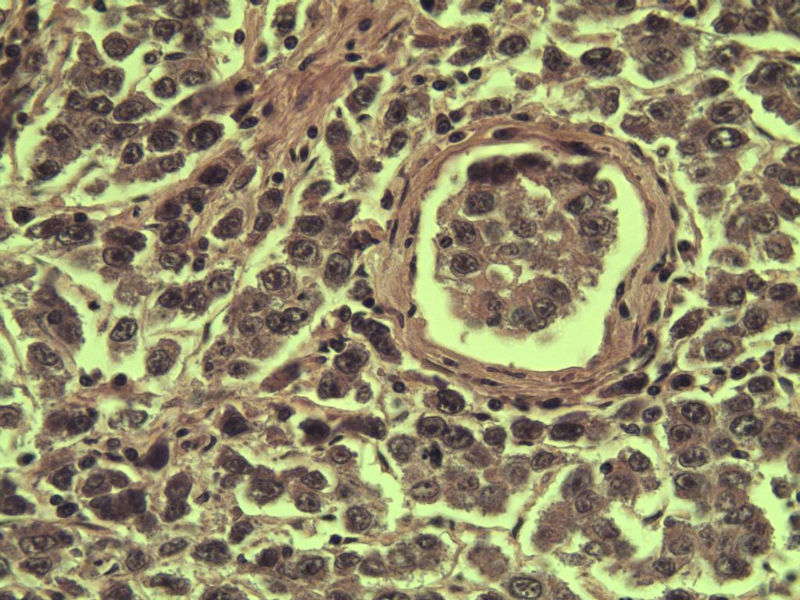
腹腔隐睾图24

男 27岁 腹腔隐睾 5*3*2 cm, 切面灰红灰黄、实性、质中,请各位老师看看,是精原细胞瘤吗?感觉不像.

名称:图1
描述:a207.Jpg.jpg

名称:图2
描述:a211.Jpg.jpg

名称:图3
描述:a212.Jpg.jpg

名称:图4
描述:a214.Jpg.jpg

名称:图5
描述:a208.Jpg.jpg

名称:图6
描述:a213.Jpg.jpg

名称:图7
描述:a209.Jpg.jpg

名称:图8
描述:a206.Jpg.jpg

名称:图9
描述:a210.Jpg.jpg

名称:图10
描述:a223.Jpg.jpg

名称:图11
描述:a215.Jpg.jpg

名称:图12
描述:a221.Jpg.jpg

名称:图13
描述:a218.Jpg.jpg

名称:图14
描述:a219.Jpg.jpg

名称:图15
描述:a216.Jpg.jpg

名称:图16
描述:a222.Jpg.jpg

名称:图17
描述:a220.Jpg.jpg

名称:图18
描述:a217.Jpg.jpg

名称:图19
描述:a224.Jpg.jpg

名称:图20
描述:a232.Jpg.jpg

名称:图21
描述:a226.Jpg.jpg

名称:图22
描述:a233.Jpg.jpg

名称:图23
描述:a228.Jpg.jpg
名称:图24
描述:a229.Jpg.jpg

名称:图25
描述:a225.Jpg.jpg

名称:图26
描述:a230.Jpg.jpg

名称:图27
描述:a223.Jpg.jpg

名称:图28
描述:a234.Jpg.jpg